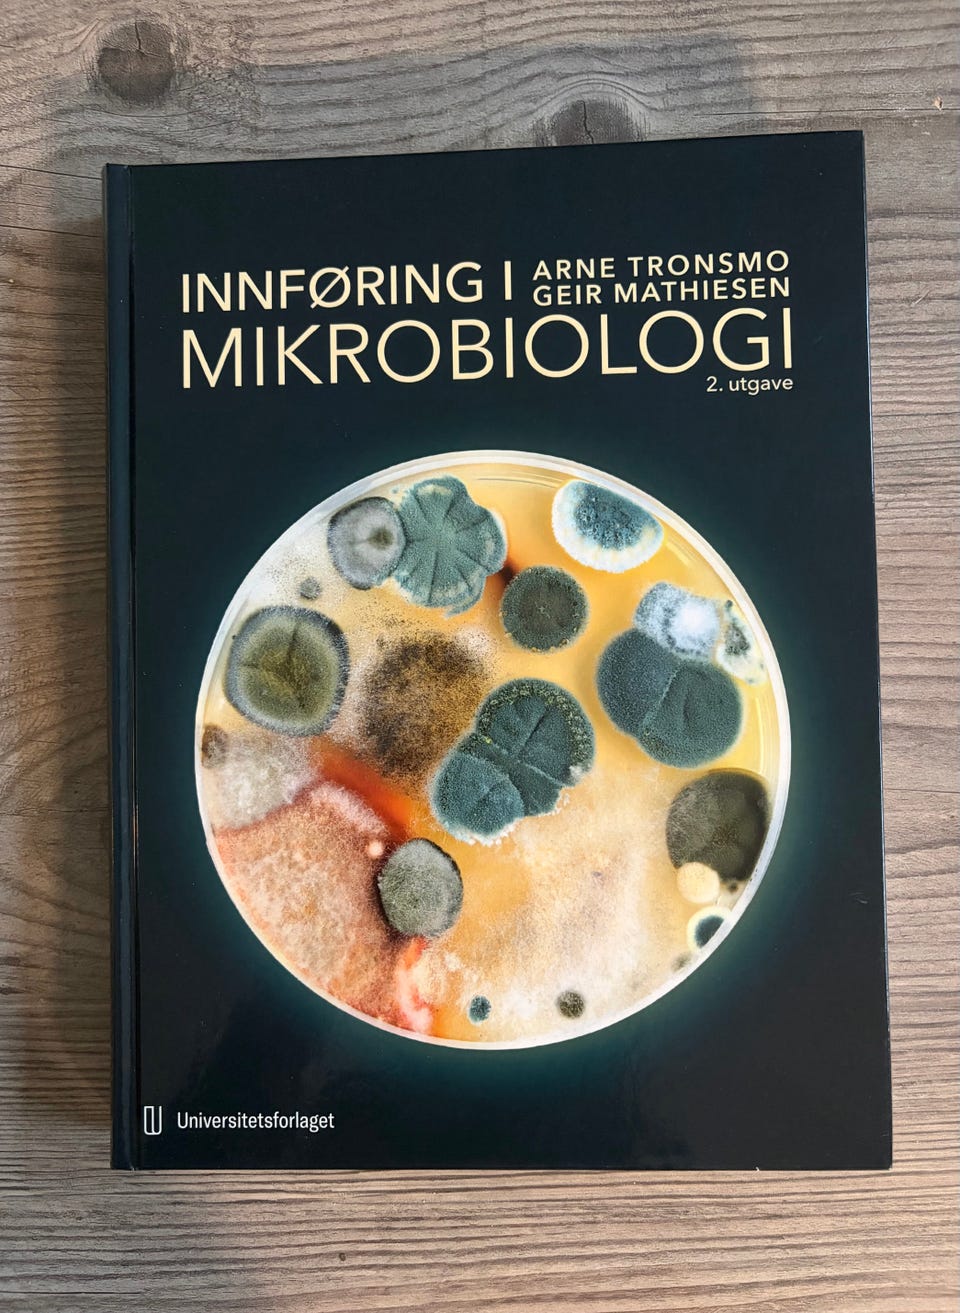
Galleribilde

Bildegalleri
(1/5)
Pensumbøker NMBU
Inaktiv
Til salgs
50 kr
Beskrivelse av varen
Tilstand: Pent brukt - I god stand
Emne: Biologi
Stern’s introductory plant biology - 600kr
Hva er økologi - 150kr SOLGT
Raven biology of plants - 900 kr
Innføring i mikrobiologi - 500kr
Alle bøkene ble kjøpt nye. Kan hentes i Ås eller sendes
NB: Knappen for å vise hele beskrivelsen har kun en visuell effekt.
Brukerprofil

Du må være logget inn for å se brukerprofiler og sende meldinger.
Logg innAnnonsens metadata
Sist endret: 23.1.2026 kl. 08:18 ・ FINN-kode: 446881525
Utforsk våre nye sider for klær og mote
Ta en titt